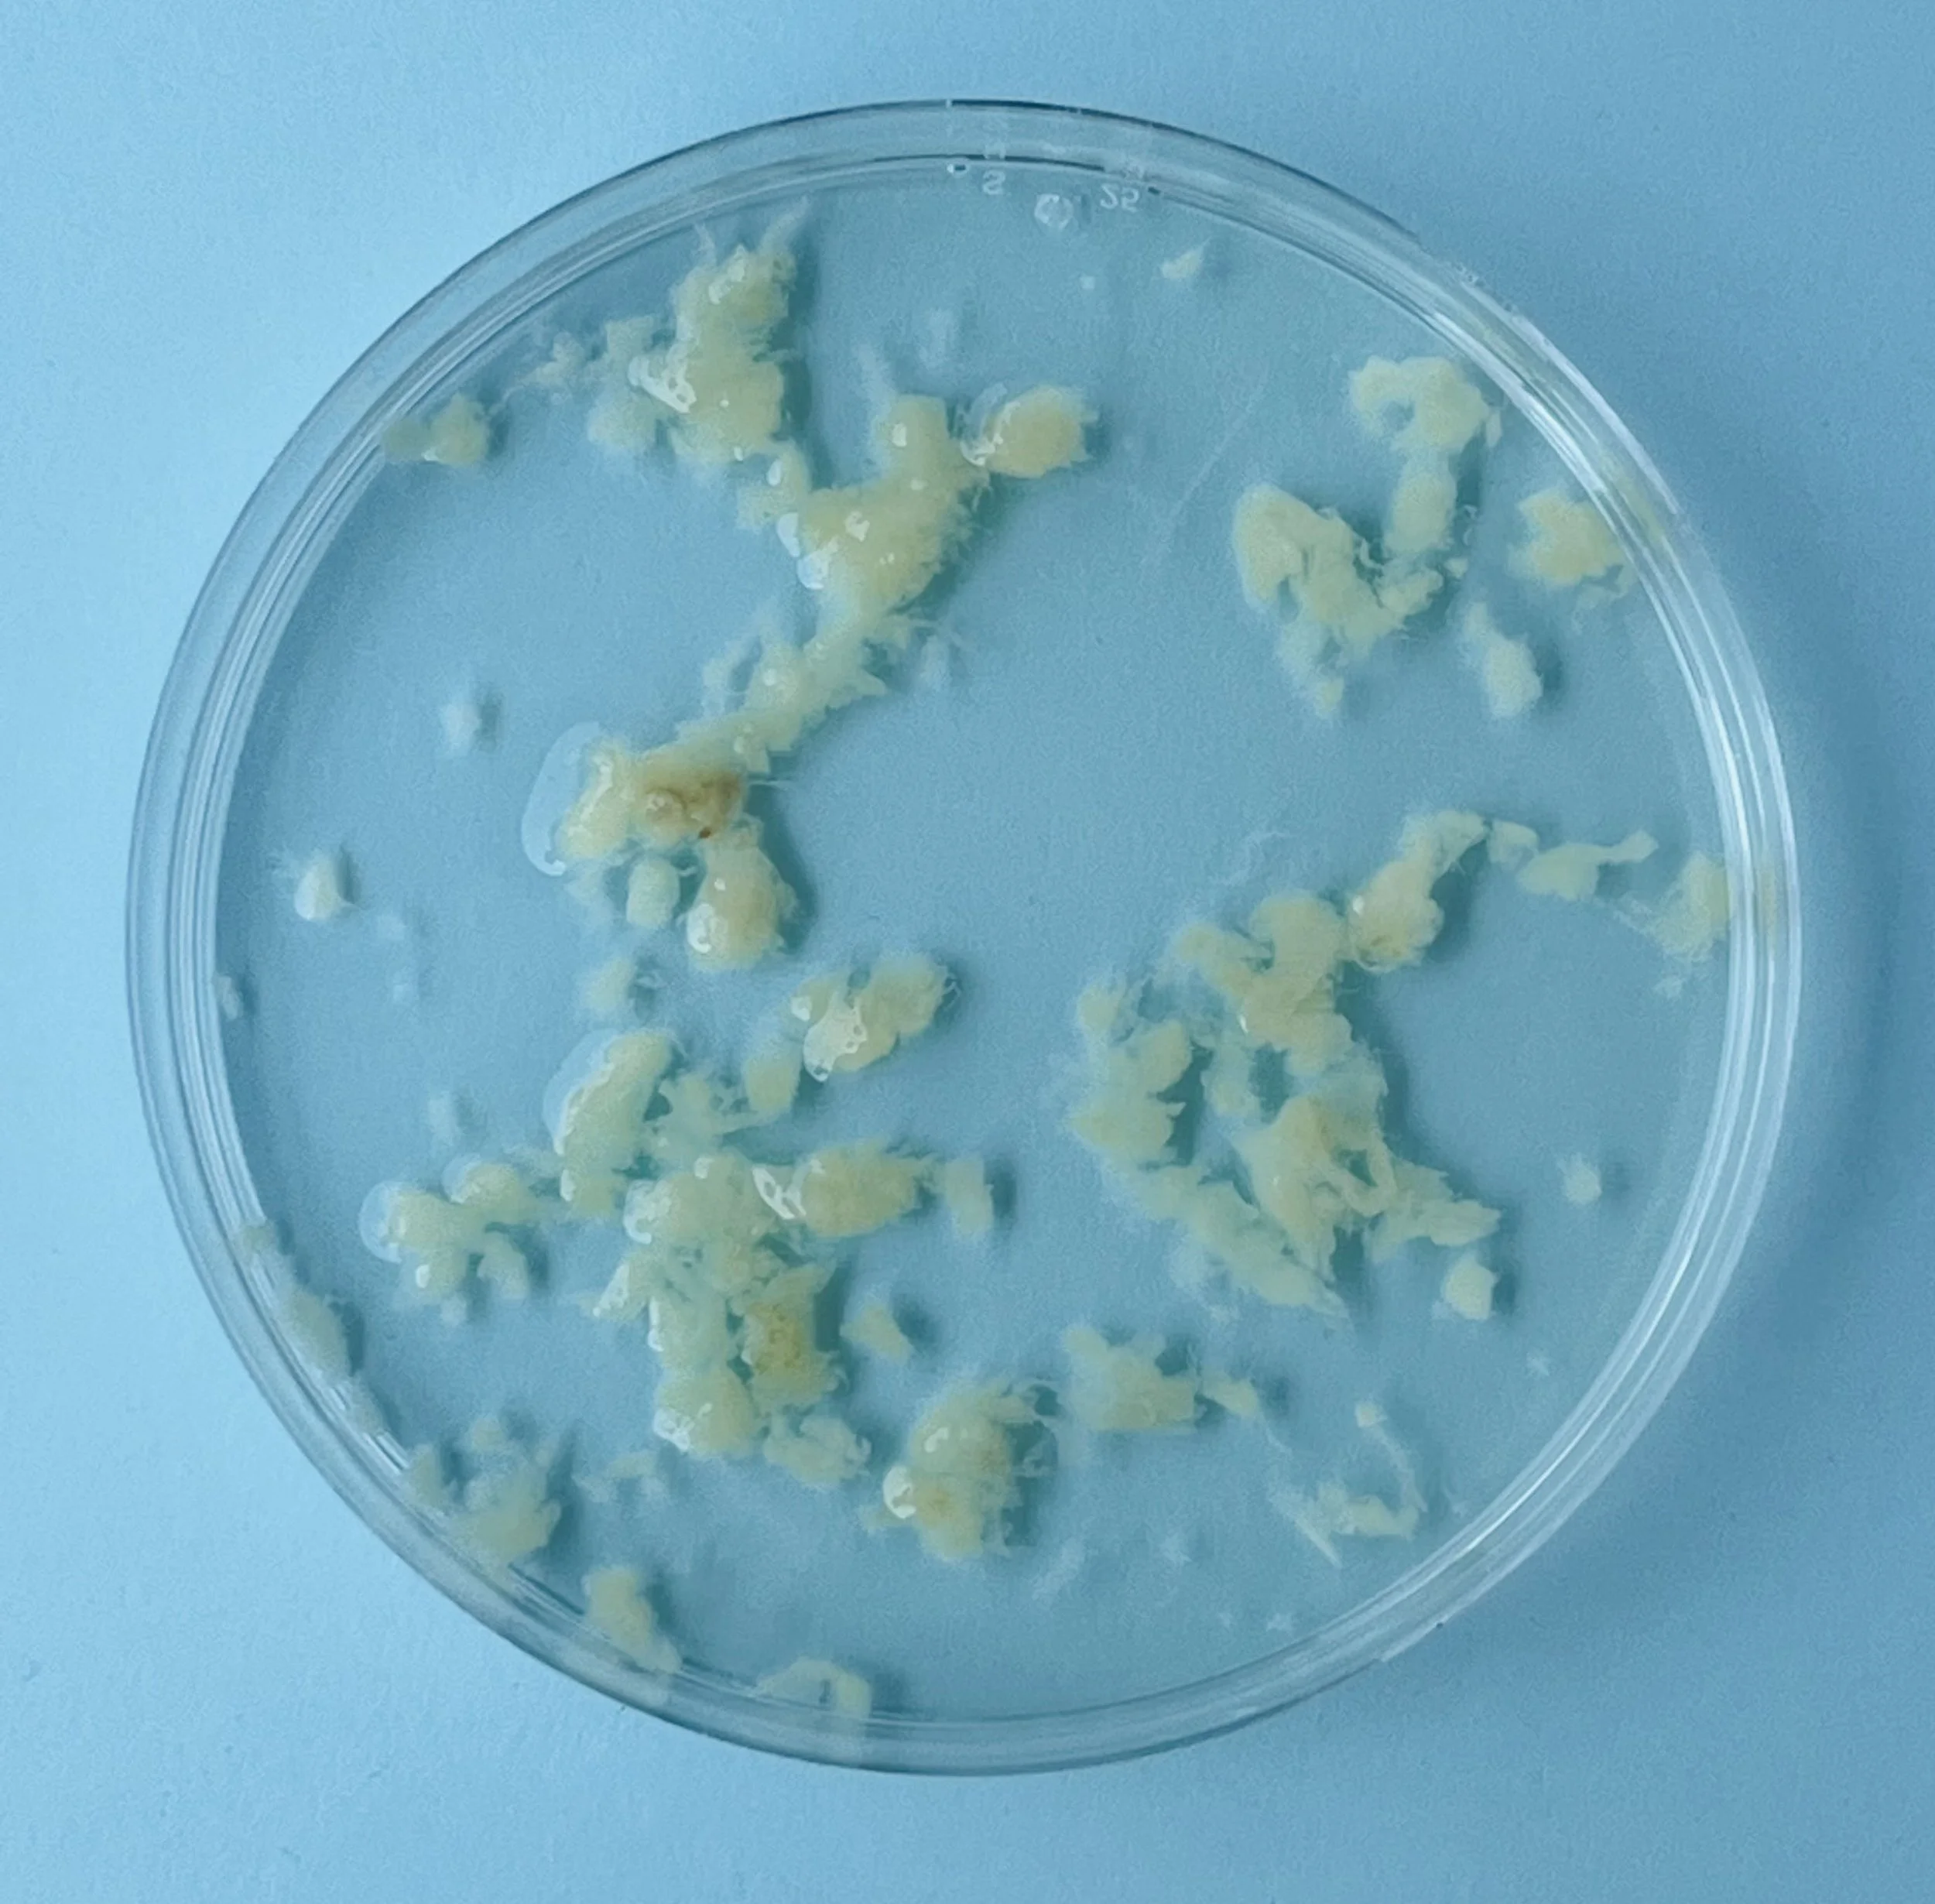
Welke woorden en beelden gebruik je voor embryo’s uit het lab?

Ik ben Lianne. Freelance verhalenmaker. Gespecialiseerd in het begrijpelijk en aantrekkelijk maken van complexe ideeën.
projecten
publicaties
Featured

Karlijn Roex: ‘Als je eenmaal gezien wordt als verward persoon, kun je niets beginnen’
Ruimte voor iets nieuws
Neem contact met mij op als je ideeën hebt voor een nieuw project of product om filosofie of wetenschap aantrekkelijk te maken voor een breed publiek. Ik denk graag met je mee.